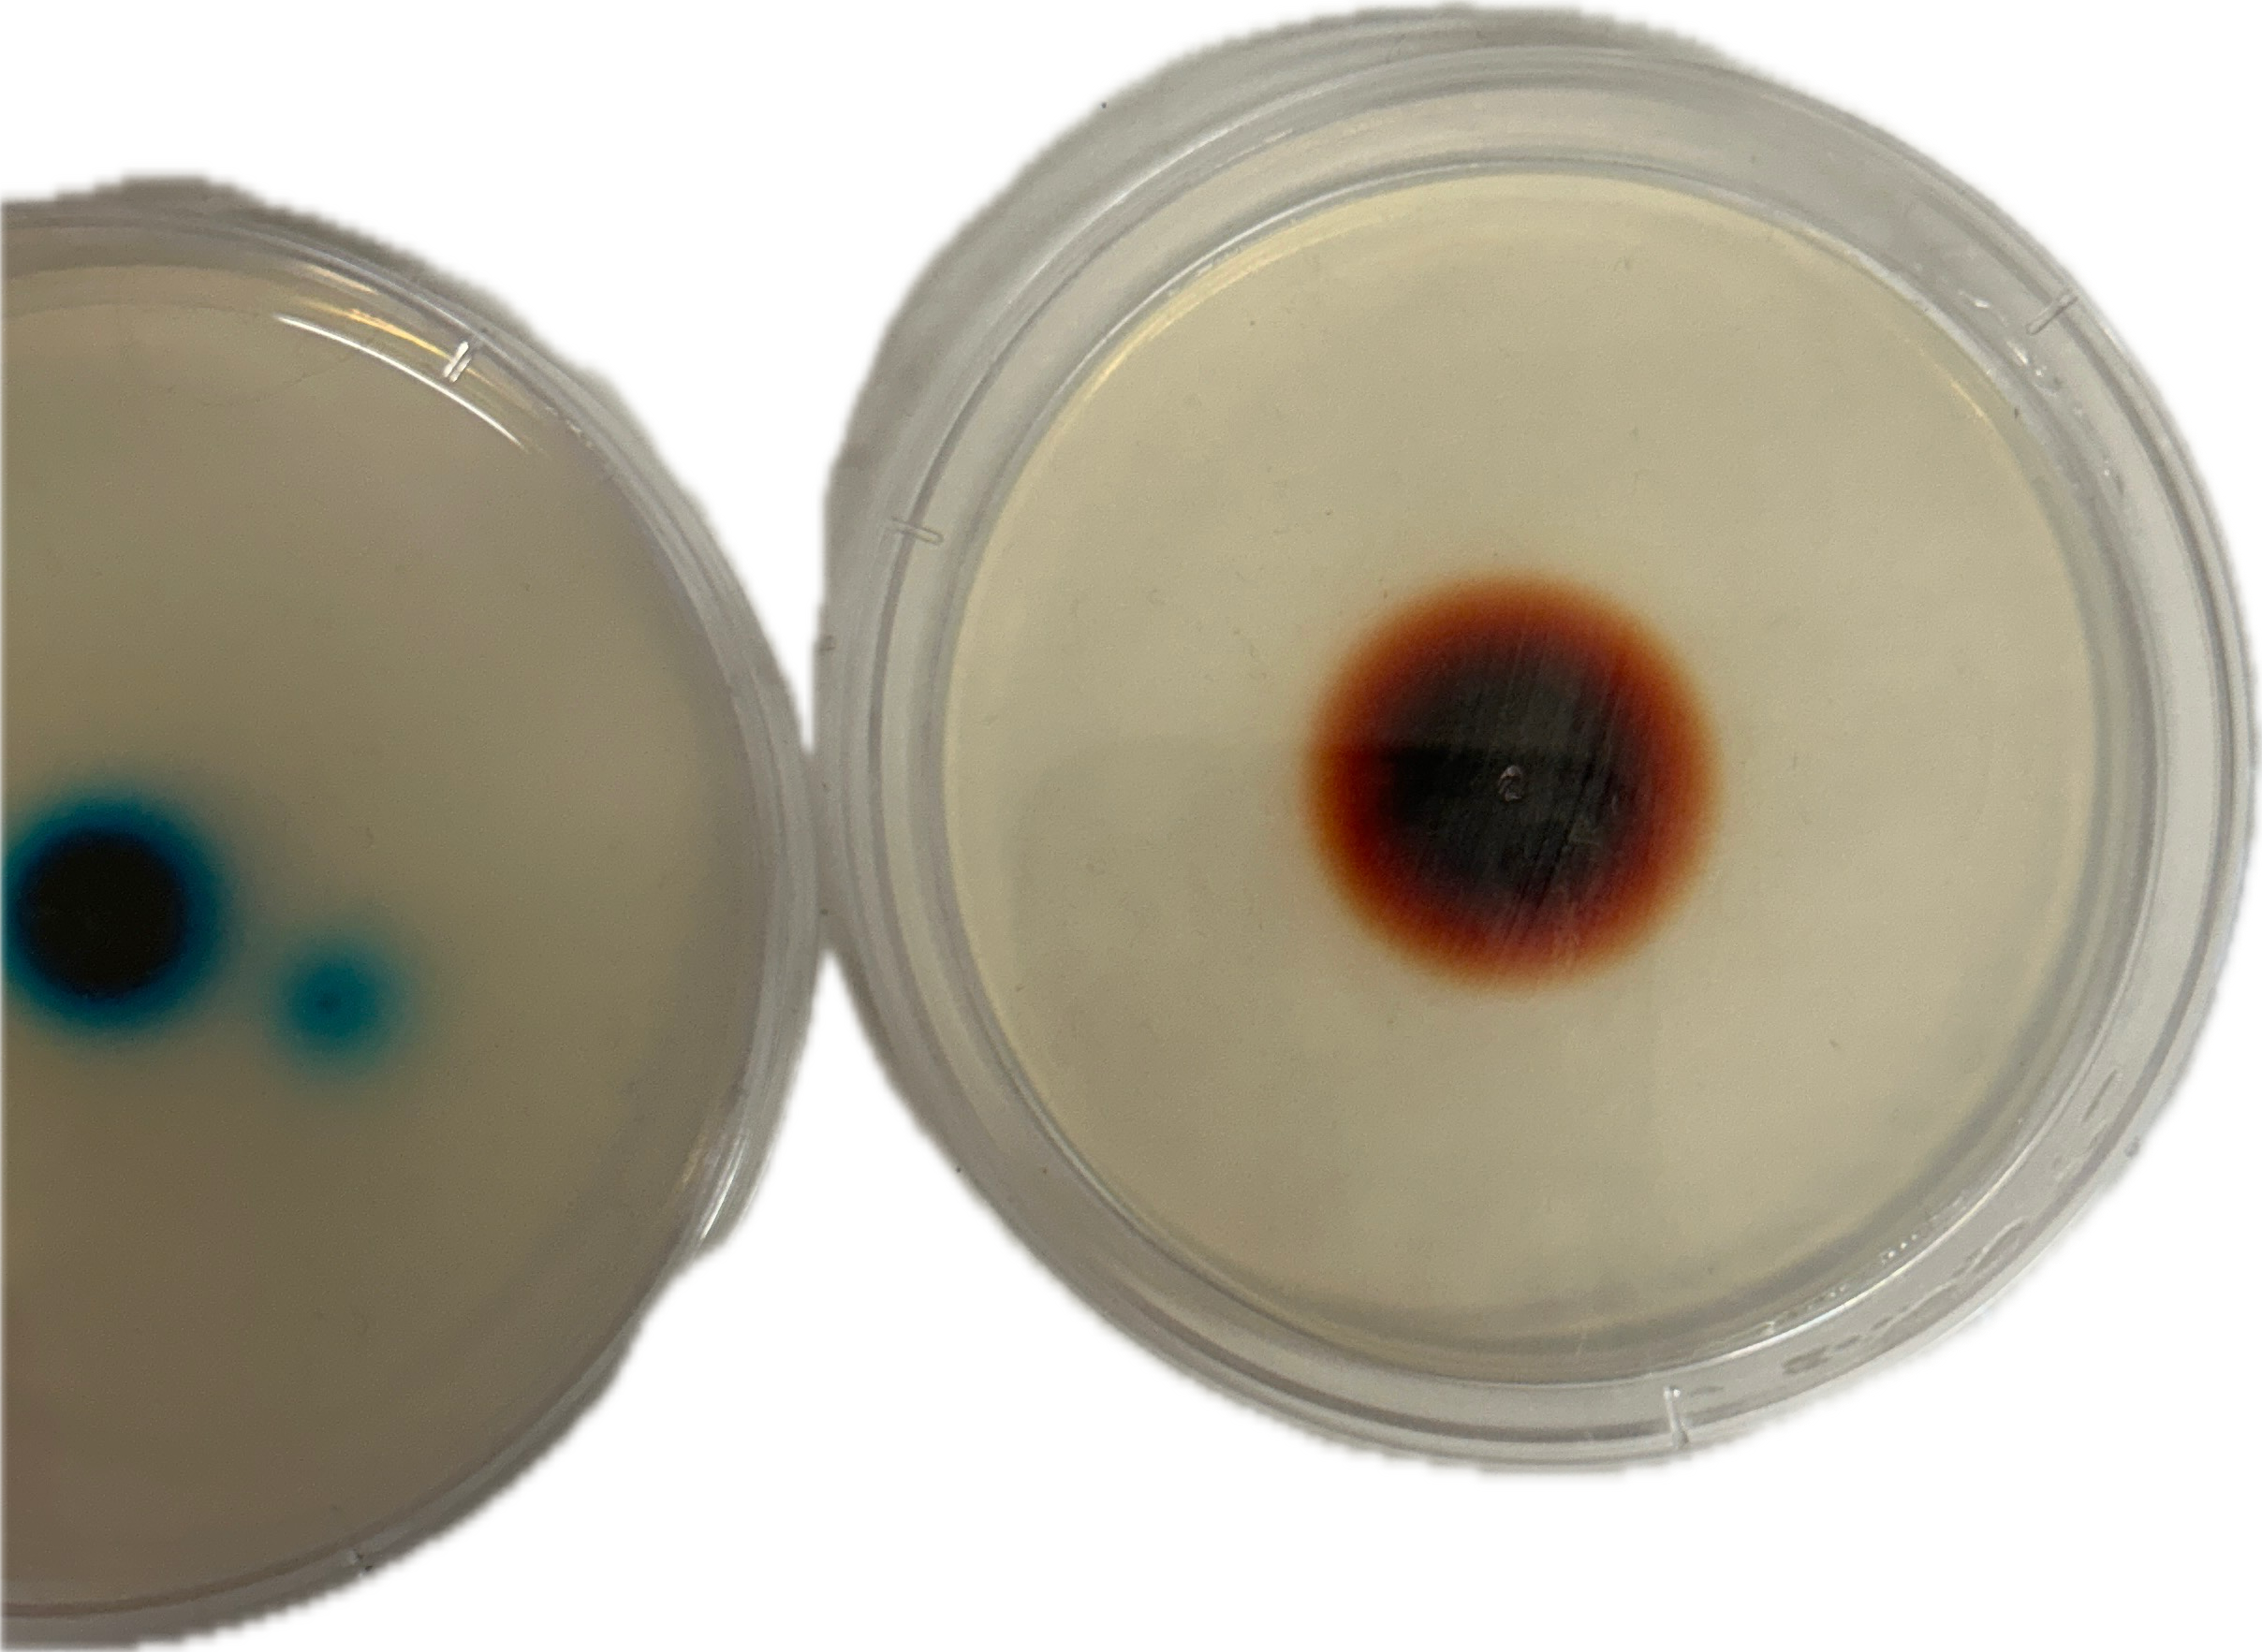
<p>Would  this contain a higher or lower rate of diffustion (right)</p>
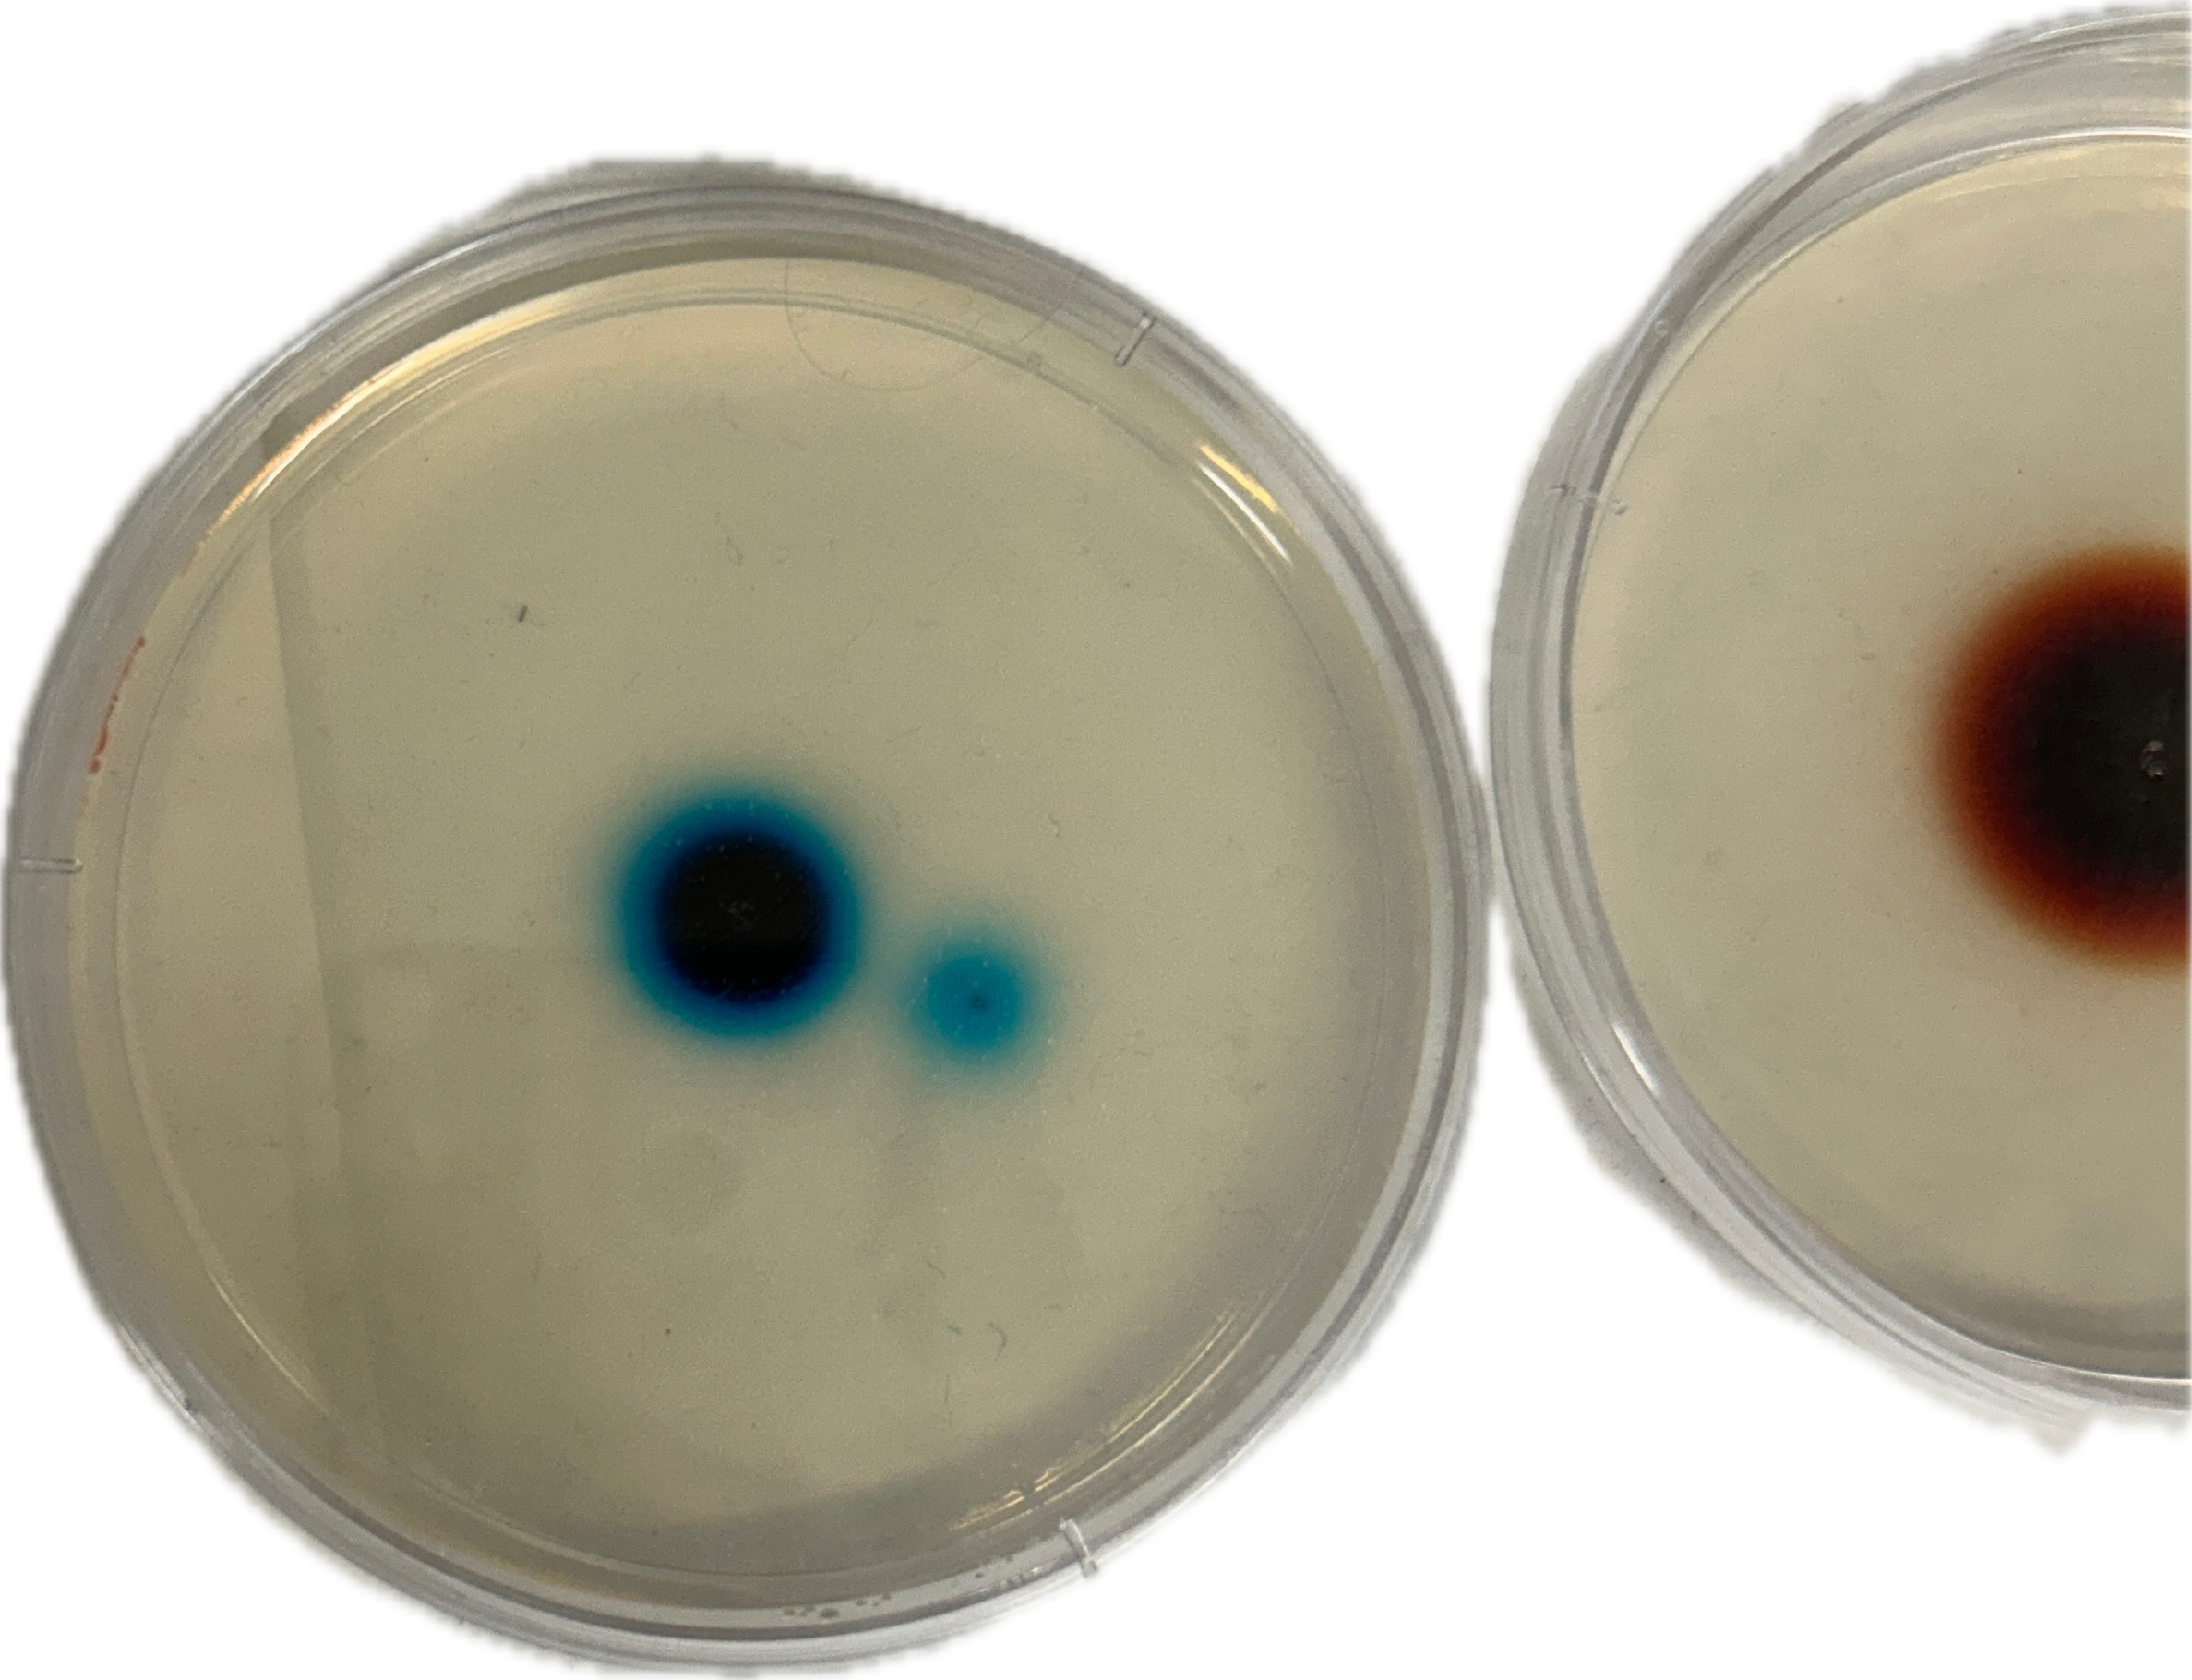
<p>Would  this contain a higher or lower rate of diffustion (left)</p>
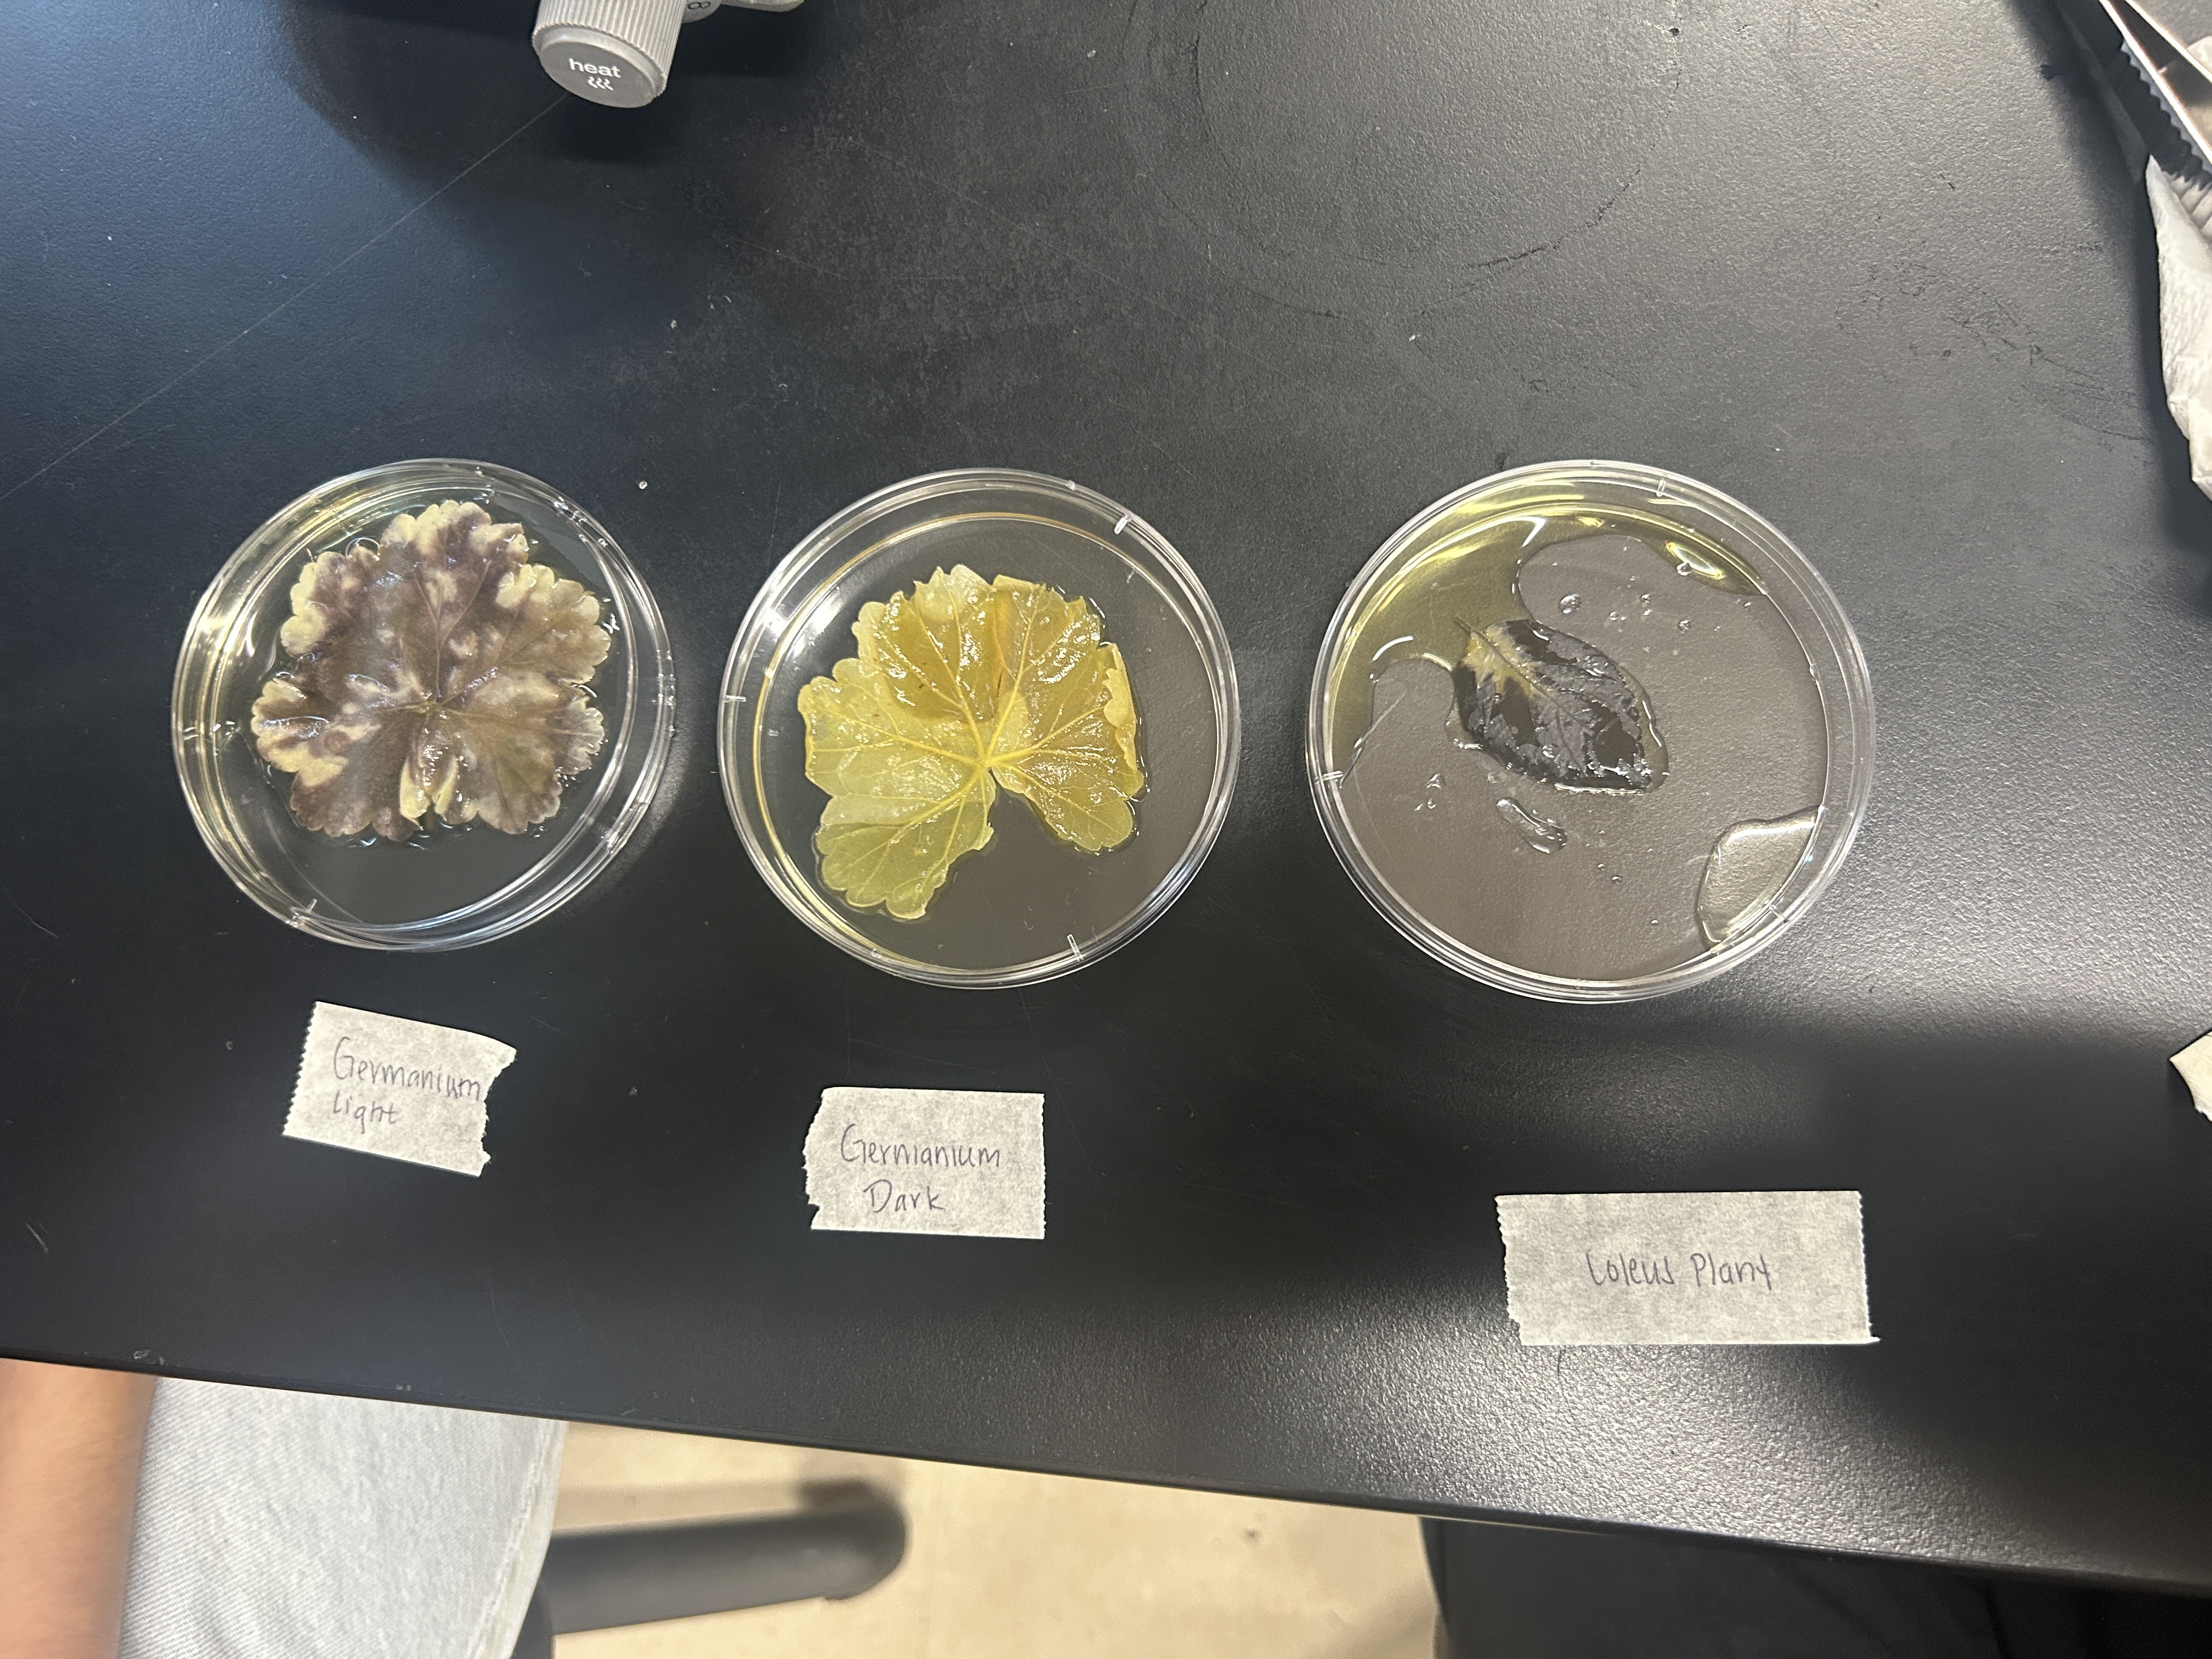
<p>Why did we bleach the leaves?</p>
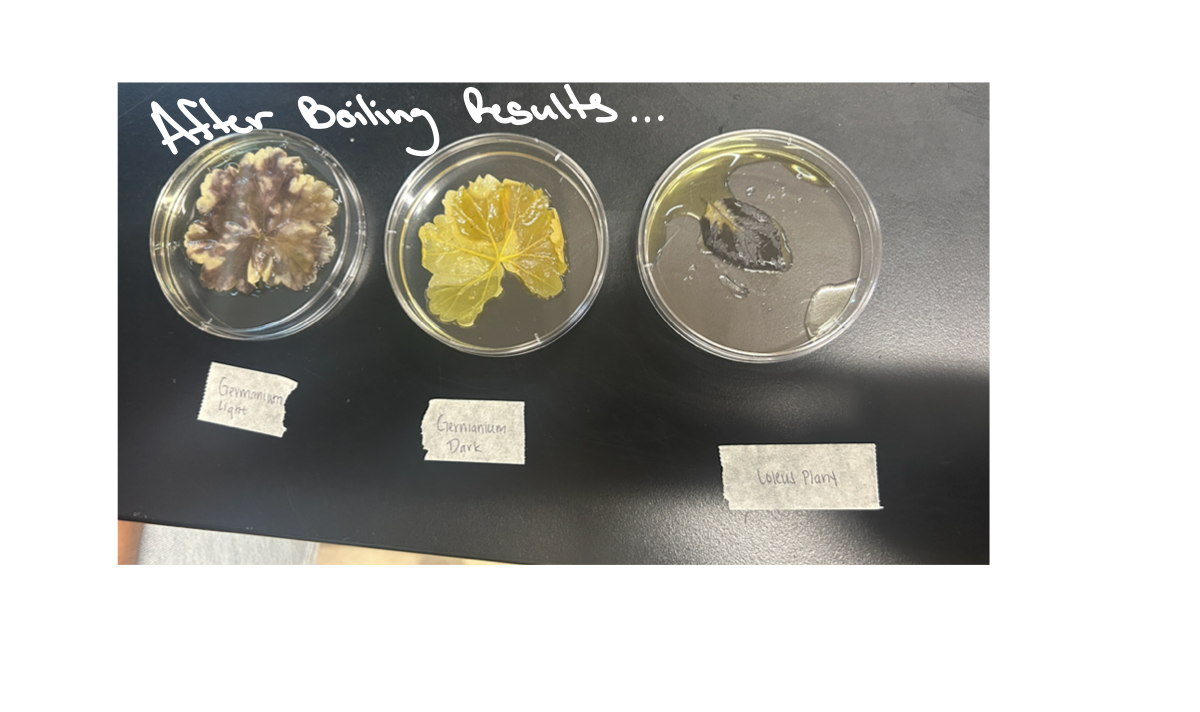
<p>What does more staining mean?</p>

Biology Lab exam #1
1/98
There's no tags or description
Looks like no tags are added yet.
Name | Mastery | Learn | Test | Matching | Spaced | Call with Kai |
|---|
No analytics yet
Send a link to your students to track their progress
99 Terms
Why do we make dilutions
Experiments require specific concentrations. If something is too concentrated, it can Damage/ Disintegrate cells. Along with with space limitations.

What does the Benedict Test for/detect?
Reducing Sugars (like glucose)

In the Benedict Test, if it was positive, what does the color change / stay to?
Green → Yellow → Orange→ Red

In the Benedict Test, if it was negative, what does the color change/stay to?
Blue
What does the Iodine Test for/detect?
Starch (polysaccharide)

In the Iodine Test, if it was positive, what does the color change / stay to?
Blue-black/ Dark purple

In the Iodine Test, if it was positive, what does the color change / stay to?
Reddish orange

What does the Biuret Test for/detect?
Proteins (Peptide bonds)

In the Biuret Test, if it was positive, what does the color change / stay to?
Purple/ Violet

In the Biuret Test, if it was negative, what does the color change/stay to?
Blue
What does the Sudan IV Test for/detect?
Lipids (fats/oils)

In the Sudan IV Test, if it was positive, what does the color change/stay to?
Red/Orange droplets or a separated red layer (looks like oil separating from water)

In the Sudan IV Test, if it was negative, what does the color change/stay to?
Orange/Red (no separation)
What does a negative control mean (In the Benedict, Iodine, Biuret, and Sudan Iv Test)
It’s just water.
What is Prokaryotic
Cells that lack a nucleus and membrane-bound.
What are Eukaryotic Cells
Cella that contain a nucleus and haves a membrane-bound Organelles

Is this a Prokaryotic or Eukaryotic Cell
Eukaryotic Cell

Is this a Prokaryotic or Eukaryotic Cell
Eukaryotic Cell

Is this a Prokaryotic or Eukaryotic Cell
Eukaryotic Cell

Is this a Prokaryotic or Eukaryotic Cell
Eukaryotic Cell

Is this a Prokaryotic or Eukaryotic Cell
Eukaryotic Cell

Is this a Prokaryotic or Eukaryotic Cell
Eukaryotic Cell
What does a Plant Cell look like

What does an Animal Cell look like


Does this contain a Chromoplasts or Chloroplasts
Chromoplasts

Does this contain a Chromoplasts or Chloroplasts
Chloroplasts

Is this a Prokaryotic or Eukaryotic Cell
Prokaryotic

Is this a Prokaryotic or Eukaryotic Cell
Prokaryotic
What is an Amyloplasts?
Organells in plant calls that store starch/ filled with starch.
What color are amyloplasts after iodine staining?
Blue-Black/ Dark purple


In this Plant cell, what is the arrow pointing to?
Amyloplast

In this Purple stain Human cell what is this
Cell Membrane

In this Purple stain Human cell what is this
cytoplasm

In this Purple stain Human cell what is this
Nucleus

In this Plant Cell, what is the arrow pointing to?
Amylopasta

In this Plant Cell, what is the arrow pointing to?
Cell Wall

In this Plant Cell, what is the arrow pointing to?
Cytoplasm
Plant Cells contain…
Cell wall, Cell membrane, Cytoplasm, Chrorplasm (some) , Amyloplasts & Nucleus.

Plant cell and Animal Cell Image difference
Would higher or lower molecular weight diffuse faster? Why?
Small/lighter molecules because it moves through the medium faster.
What is diffusion ?
Movement of molecules from high → low concentration
(Looking at the size of the colored halos)
Would a larger ring/halo indicate higher or lower rate of diffusion.
Higher rate of diffusion.
Is Iodine or starch moving through the membrane.
Iodine moves through bcz it’s small, starch does not move, it's too large and stay inside.
Which properties responsible for movement through the membrane.
Size of the molecule.
What is hypertonic.
Solution has higher solute → water leaves blood cells
What is hypotonic?
Solution has lower solute → water enters cell
What is isotonic?
Solution has equal solute → no water movement
What is hydrophilic?
"Water loving” → molecules that mix well with water
What is a hydrophobic?
“Water fearing“ → molecules that do not mix with water
What is osmosis?
Moment of water across membrane to balance solute concentration
What happens if potato cylinders are in a hypotonic solution?
Water enters → mass/length increases
What happens in a hypertonic solution
Water leaves→ mass/length decreases
What happens to plant cells in a hypotonic solution?
Water enters→ so becomes normal.

What happens to a plant cell in a hypertonic solution?
Water leaves→ membrane pulls away→ plasmolyze


What happens to animal cells in a hypotonic solution.
Water enters → Lyses
What happened to animal cells in a hypertonic solution?
Water leaves→ cell crenate
Would this contain a higher or lower rate of diffustion (right)
Higher
Would this contain a higher or lower rate of diffustion (left)
Lower

Isotonic, Hypotonic, & Hypertonic chart
Closest to zero out all the given info = isotonic (only one) (can be a negative number)
Positive→ Hypotonic → water entered the cell
Negative → Hypertonic → cell losses water
Does extreme heat or extreme cold cause more extensive damage to beat cell membranes? Why?
Extreme cold causes more excessive damage
Which causes more membrane damage, methanol or acetone?
Acetone causes more damage than methanol

Which one shows the most amt of membrane damage. ( numbers from left to right)
#6

Which one shows the most amt of membrane damage. ( numbers from left to right)
#6

What is the optimal temperature?
40 C

What temperature is the enzyme denatured?
80 C

What is the optimal pH?
pH 7

What pH is the enzyme denatured?
pH 2 and 10+

What gas is produced during these antibiotic fermentation
Carbon Dioxide (CO2)

Which is the Activator
3

Which are Inhibitor
1

What does this measure?
Fermentation/ CO2 production
What does RF values represent?
Distance traveled by pigment

Based on the info given, which best correlates with C?
Xanthophyll

Based on the info given, which best correlates with E?
Carotene

Based on the info given, which best correlates with A?
Chlorophyll B
what technique is looking RF values to determine distance traveled called?
Paper Chromatography

What does Sodium Bicarbonate Supply
CO2

What are the Bubbles made of?
Oxygen gas
Why did we bleach the leaves?
To remove chlorophyll

What does the iodine stain for?
Starch
What does more staining mean?
More starch → more photosynthesis occurred/rate..

What does less or no staining mean?
no starch → less/no photosynthesis occurred/rate.

What phase of mitosis is this?
Interphase

What phase of mitosis is this?
Prophase

What phase of mitosis is this?
Metaphase

What phase of mitosis is this?
Anaphase

What phase of mitosis is this?
Telophase

What phase of mitosis is this?
Interphase

What phase of mitosis is this?
Prophase

What phase of mitosis is this?
Metaphase

What phase of mitosis is this?
Telophase

What phase of mitosis is this?
Anaphase

What phase of mitosis is this?
Telophase

Is this gamete a Female or Male?
Female

Is this gamete a Female or Male?
Male

is this a haploid or diploid?
Haploid

is this a haploid or diploid?
Haploid

Is this Meiosis or Mitosis?
Meiosis

Is this Meiosis or Mitosis?
Meiosis